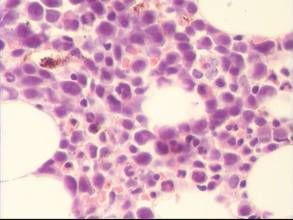
全血細胞減少症

疾病名稱
全血細胞減少症
疾病別名
再生障礙性貧血再障(免疫相關性全血細胞減少症例外)
疾病分類
普通外科 血液科
疾病描述
全血細胞減少症又名再生障礙性貧血(再障),是骨髓造血功能衰竭所導致的一種全血減少綜合徵。
症狀體徵
肝、脾腫大、腹水、黃疸。
治療方案
全血細胞減少症
全血細胞減少症術前準備:
1.對門靜脈高壓患者,術前應改善肝功能,糾正出血傾向。
2.對某些嚴重貧血者,應反覆多次輸血後,再行脾切除。
3.對長期使用激素者,應預防性使用抗生素。
4.按普外科腹部手術前準備。
麻醉要求:
氣管內插管麻醉。
術中注意點:
1.手術可取左側肋緣下或上腹正中“L”形切口,術野顯露充分。
2.切睥前宜先結紮脾動脈。
3.脾切除後,脾窩應放置引流管。
4.血液病患者須將副脾一併切除。
5.切除脾臟時注意不要損傷胰尾部,以免術後發生胰瘺。
術後處理:
1.按一般腹部手術後處理。
2.引流管一般於術後24~48h拔除。
3.術後每日查白細胞和血小板。術後當血小板超過(0.8~1)×1012/L時,應行抗凝治療。

